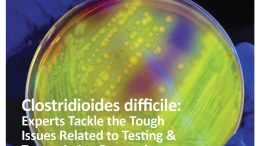

The Jan-Feb 2026 Issue of Healthcare Hygiene Magazine is Now Available
In the December 2025 SHEA Town Hall, “Cracking C. Diff: Evidence-based Approaches & Real-World Impact,” panelists tackled the hard questions related to addressing one of healthcare’s most formidable foes. Access…